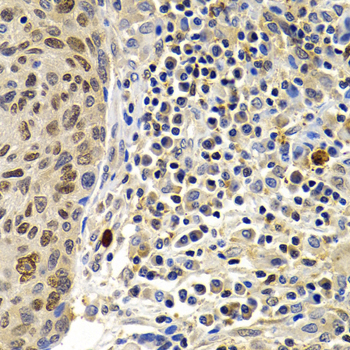

For quotations, please use our online quotation form, and you may also contact us by
sales@neoscientific.com
+1-888.733.6849
+1-617.299.7367 (Int’l)
+1-888.733.6849
+1-617.299.7367 (Int’l)
| Reactivity | Human Mouse Rat |
| Tested applications | WB IHC |
| Recommended Dilution | WB 1:500 - 1:1000 IHC 1:50 - 1:100 |
| Calculated MW | 18kDa |
| Observed MW | Refer to Figures |
| Immunogen | Recombinant protein of human SUMO2 |
| Storage Buffer | Store at -20℃. Avoid freeze / thaw cycles. Buffer: PBS with 0.02% sodium azide, 50% glycerol, pH7.3. |
| Concentration | hop |
| Synonym | SUMO2;HSMT3;MGC117191;SMT3B;SMT3H2;SUMO3;Smt3A;HSMT3;SMT3 homolog 2;SUMO-3;Sentrin-2 ; Ubiquitin-like protein SMT3A ; |

Western blot analysis of extracts of various cell lines, using SUMO2 antibody.

Immunohistochemistry of paraffin-embedded rat lung using SUMO2 antibody at dilution of 1:200 (400x lens).

Immunohistochemistry of paraffin-embedded rat kidney using SUMO2 antibody at dilution of 1:200 (400x lens).
Immunohistochemistry of paraffin-embedded human lung cancer using SUMO2 antibody at dilution of 1:200 (400x lens).

Immunohistochemistry of paraffin-embedded human kidney cancer using SUMO2 antibody at dilution of 1:200 (400x lens).

Immunohistochemistry of paraffin-embedded human stomach cancer using SUMO2 antibody at dilution of 1:200 (400x lens).
Small ubiquitin-related modifier 1, 2 and 3 (SUMO-1, -2 and -3) are members of the ubiquitin-like protein family (1). The covalent attachment of the SUMO-1, -2 or -3 (SUMOylation) to target proteins is analogous to ubiquitination. This post-translational modification is a reversible, multi-step process that is initiated by cleaving a precursor protein to a mature protein. Mature SUMO-1, -2 or -3 is then linked to the activating enzyme E1, conjugated to E2 and in conjunction with E3, SUMO-1, -2 or -3 is ligated to the target protein (2). Ubiquitin and the individual SUMO family members are all targeted to different proteins with diverse biological functions. Ubiquitin predominantly regulates degradation of its target (1). In contrast, SUMO-1 is conjugated to RanGAP, PML, p53 and IκB-α to regulate nuclear trafficking, formation of subnuclear structures, regulation of transcriptional activity and protein stability (3-7). SUMO-2/-3 forms poly-(SUMO) chains, is conjugated to topoisomerase II and APP, regulates chromosomal segregation and cellular responses to environmental stress, and plays a role in the progression of Alzheimer disease (8-11).
N/A